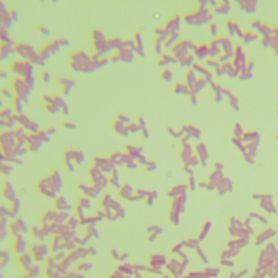
产品封面图

万千商家帮你免费找货
0 人在求购买到急需产品
- 详细信息
- 文献和实验
- 技术资料
- 库存:
100
- 英文名:
Enterococcus casseliflavus
- 保质期:
6年
- 供应商:
优利科(上海)生命科学有限公司
- 保存条件:
2-8℃
- 规格:
冻干粉
铅黄肠球菌菌种简介:
| 菌种名称 |
铅黄肠球菌 |
| 规格 |
冻干粉 |
| 生长条件 |
37℃;18-24h;好氧 |
| 菌种主要应用 |
研究;教学 |
铅黄肠球菌大小:1-2mm 形状:圆形 边缘:整齐 透明度:不透明 颜色:浅黄色 隆起度:中间凸起 表面:明亮光滑 质地:湿润粘稠
保存条件:2-8℃
安瓿管开封步骤:


铅黄肠球菌传代方法:①准备1支含有5~10mL液体培养基的试管和2个平板;②安全柜中打开,用酒精灯灼烧顶部,后迅速滴上无菌水使之破裂,随后用镊子将其敲碎;③吸取0.5mL液体培养基打入冻干管,充分溶解后重新打回液体试管中,混匀;④吸取0.2mL菌悬液打入平板中,涂布均匀,重复两次获得两个平板;⑤将液体试管和平板全部置于上述培养条件下培养,菌种长出即可使用。
培养基:胰蛋白胨大豆培养基(TSA/TSB):胰蛋白胨 17.0g,大豆胨 3.0g,氯化钠 5.0g,磷酸氢二钾 2.5g,葡萄糖 2.5g,琼脂 20.0g(液体培养基不含),蒸馏水 1.0L,pH 7.3±0.2。121℃,15min灭菌。
注意事项
1 微生物菌种应保存于低温、清洁和干燥的地方,室温放置时间过长会导致菌种衰退;
2 菌种操作在无菌条件下进行,接种完毕应该灭菌再做丢弃处理;
3 斜面菌种和穿刺菌种保存时间通常为3-6个月,应根据菌种状况及时结转;冻干粉保存时间通常是2-25年;甘油菌保存时间为2-5年。

活化步骤图:

铅黄肠球菌相关产品:
| 珊瑚色诺卡氏菌 | 工业污水净化。 |
| 玫瑰产色链霉菌 | |
| 蛎灰链霉菌 | 抑制革兰氏阳性细菌、产生蛎灰霉素(属美加霉素类群)。 |
| 玫瑰褐链霉菌 | 抑制革兰氏阳性细菌、革兰氏阴性细菌和丝状真菌。 |
| 孔雀石绿链霉菌 | |
| 淡紫灰链霉菌 | |
| 吸水链霉菌紫色变种 | |
| 刺孢吸水链霉菌昆明变种 | 产正放线酮类物质,能防治小麦锈病。 |
| 紫色直丝链霉菌 | 抑制革兰氏阳性细菌和丝状真菌。 |
| 刺孢吸水链霉菌 | 产正放线酮,可防治多种植物真菌病害。 |
| 弗氏链霉菌 | 产新霉素和弗氏菌素。 |
| 黄直丝链霉菌 | |
| 淡天蓝色链霉菌 | 能防治烟草赤星病,对阳性细菌、大肠杆菌、白色假丝酵母无作用。 |
| 天蓝色链霉菌 | 抑制阳性细菌,产生石蕊杀菌素和链丝兰素。 |
| 抗生链霉菌 | 产生放线/菌素A、B。 |
| 白浅灰链霉菌 | 产生新霉素复合体。 |
| 大丽花轮枝孢 | 棉花黄萎病菌。 |
| 出芽短梗霉 | 腐蚀油漆。 |
| 赭绿青霉 | 耐高浓度硫酸铜 |
| 黑曲霉 |
风险提示:丁香通仅作为第三方平台,为商家信息发布提供平台空间。用户咨询产品时请注意保护个人信息及财产安全,合理判断,谨慎选购商品,商家和用户对交易行为负责。对于医疗器械类产品,请先查证核实企业经营资质和医疗器械产品注册证情况。
文献和实验(-)、部分有稀疏鞭毛(铅黄肠球菌),Lancefield D 群:大多数菌株产生一种与细胞壁有关的甘油磷壁酸抗原,该抗原被确认为链球菌D 群抗原(80%),适宜温度35-37℃ 大多数细菌在10℃ 和45℃ 生长。 (二)菌落特征BA:灰白色、不透明、表面光滑、直径0.5-1 mm、α-、不溶血、少数β-中国蓝/伊红亚甲蓝/麦康凯/SS:可生长,但菌落较小,发酵乳糖的菌株可形成蓝色或粉红色小菌落。液体培养基:均匀浑浊生长。 (三)生化反应PYR(+) 盲肠肠球菌、哥伦比亚内肠球菌、解糖肠球菌例外LAP
为革兰阳性,成双或短链状排列的卵圆形球菌,无芽胞,无荚膜,部分肠球菌有稀疏鞭毛。 营养要求高,需氧及兼性厌氧,在胆汁七叶苷和含6.5%NaCl培养基中可以生长(此点可与链球菌鉴别)。在血平板上主要表现为γ-和α-溶血。触酶阴性,多数肠球菌能水解吡咯烷酮-β-萘基酰胺(PYR)。 与同科链球菌的显著区别在于肠球菌能在高盐(6.5%NaCl)、高碱(pH9.6)、40%胆汁培养基上和10℃~45℃环境下生长,并对许多抗菌药物表现为固有耐药医|学教育网搜集整理。 目前
肠球菌属为革兰阳性,成双或短链状排列的卵圆形球菌,无芽胞,无荚膜,部分肠球菌有稀疏鞭毛。 营养要求高,需氧及兼性厌氧,在胆汁七叶苷和含6.5%NaCl培养基中可以生长(此点可与链球菌鉴别)。在血平板上主要表现为γ-和α-溶血。触酶阴性,多数肠球菌能水解吡咯烷酮-β-萘基酰胺(PYR)医`学教育网搜集整理。 与同科链球菌的显著区别在于肠球菌能在高盐(6.5%NaCl)、高碱(pH9.6)、40%胆汁培养基上和10℃~45℃环境下生长,并对许多抗菌药物表现为固有耐药